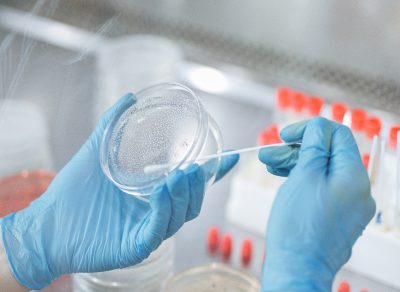

Podnieś bezpieczeństwo
i efektywność badań mikrobiologicznych
BactoMatic służy do automatyzacji prac mikrobiologicznych w przemyśle farmaceutycznym, w tym do badania czystości mikrobiologicznej produktów, wczesnego wykrywania wzrostu, oceny ilościowej oraz jakościowej kolonii drobnoustrojów hodowanych na pożywkach stałych.
Urządzenie może zostać zaadaptowane do potrzeb innych branż takich jak firmy kosmetyczne i spożywcze, służby sanitarno-epidemiologiczne, czy laboratoria badawcze i medyczne.
01
Monitorowanie kinetyki wzrostu kolonii, w tym skrócenie czasu wykrycia kolonii, dzięki hybrydowej analizie zdjęć RGB i skanu 3D.
02
Zliczanie wyrosłych kolonii drobnoustrojów z dokładnością nie mniejszą niż 95%, z określeniem ich przynależności do gatunku/rodzaju, również w hodowlach mieszanych.
03
Analizowanie wzrostu kolonii drobnoustrojów na podłożach wybiórczych, wybiórczo-różnicujących i różnicujących dzięki detekcji kolorów i ich zmian.
04
Możliwość adaptacji oprogramowania do prowadzenia diagnostyki na płytkach dwudzielnych, czy pomiarów stref zahamowania wzrostu.
05
Możliwość adaptacji oprogramowania do analizy kinetyki wzrostu na wybranych podłożach w celu różnicowania cech metabolicznych różnych szczepów drobnoustrojów.


Automatyzacja rutynowych i masowych analiz redukuje poziom błędów badawczych czystości produkcji.

Wykrycie drobnoustrojów nawet od 6 godz. pozwala szybciej zatrzymać produkcję i zredukować straty utylizacji produktu.

Specjalista mikrobiolog jest w stanie dokładniej i szybciej prowadzić wiele badań jednocześnie, redukując ilość powtarzalnej pracy do minimum.
